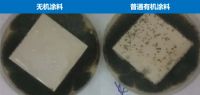
高层火灾频发再敲警钟！铃鹿无机涂料防患未然！

[房产装修家居资讯] 高层火灾频发再敲警钟!铃鹿无机涂料防患未然!
2024-11-11 20:13
近年来,国内外高层建筑火灾频发,高层建筑如果发生火灾,救援将面临快速蔓延、疏散困难、供水紧张、高度限制等问题,建筑整体的防火性能就尤为关键,选择一款扎实的防火涂料就显得格外重要了。 防火++...
>> 查看全文
[房产装修家居资讯] “4倍国标选铃鹿”,铃鹿许昌服务中心经验分享!
2024-11-11 20:13
面对仿石漆行业产品参差不齐、消费者选择困难的现状,自3月起,铃鹿就举办了“4倍国标选铃鹿”的专题活动,积极组织铃鹿专员,从报告真伪、检测机构权威性、产品性能、质保年限等...
>> 查看全文
[房产装修家居资讯] 双十一家居焕新指南 跟着优居主编收藏品质生活宝藏清单
2024-11-11 18:30
一年一度的双十一购物狂欢节来袭,在这个全民嗨购的节日里,优居新闻中心主编团化身家居甄探,凭借专业眼光与对生活的炽热洞察,甄选实用家居好物,为您精准锚定那些能让家居品质与格调直线飙升的宝藏单品,帮你轻...
>> 查看全文
[房产装修家居资讯] 振升颐人门窗“青春款”新品震撼上市,开启品质生活新篇
2024-11-11 17:57
2024 年 11 月 11 日,振升集团隆重推出了其精心研发的门窗新品:青春款静音平开窗,为市场带来了一场关于青春与创新的风暴,必将重新定义家居门窗的标准。 卓越设计,尽显美学与...
>> 查看全文
[房产装修家居资讯] 朗盛门窗X品牌力 | 贝尔113外开系统平开窗
2024-11-11 17:23
贝尔113外开系统平开窗,作为朗盛门窗的拳头产品之一,以其卓越的性能和精致的设计在市场上赢得了广泛的认可。 这款产品采用了1.8MM的6063-T5原生铝材,确保了门窗的承重抗压性能,为...
>> 查看全文